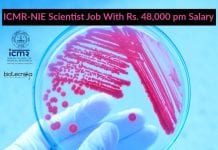
ICMR-NIE Scientist Job With Rs. 48,000 pm Salary ICMR-NIE Scientist Job

Most Detailed 3D Model Of SARS-CoV-2 Revealed!
DETAILED 3D MODEL OF SARS-COV-2 REVEALED
Scientists are gaining increasing amounts of information about the viral components that make up the infectious particles of the...
COVID-19 Of Plant World – Banana Plantations Affected Worldwide
‘Banana Covid’ Hits Plantations - COVID-19 of the Plant World
Described as the equivalent of Covid-19 in bananas by scientists, a novel fungus strain that...
NITI Aayog Biotech & Life Science Project Recruitment at ICAR-IARI
NITI Aayog Biotech & Life Science Project Recruitment at ICAR-IARI
NITI Aayog Biotech & Life Science Project Recruitment at ICAR-IARI. Biotechnology/ Biochemistry / Life Science...
ICMR-NIE Scientist Job With Rs. 48,000 pm Salary
ICMR-NIE Scientist Job With Rs. 48,000 pm Salary
ICMR-NIE Scientist Job With Rs. 48,000 pm Salary. Research vacancies for mac .phdmicrobiology and epidemiology candidates at...
Biotecnika Times – Newsletter 29.05.2020 – CUCET 2020, NII Cancer Project Msc Job, DU...
Biotecnika Times - CUCET 2020, NII Cancer Project Msc Job, DU Job
Delhi University Project Assistant Job – Biotech / Life Science / Microbiology
Delhi University...
Life Sciences Project JRF Position Available at Ahmedabad University
Life Sciences Project JRF Position Available at Ahmedabad University
About the School of Arts and Sciences
The School of Arts and Sciences at Ahmedabad University currently...
Genpact Life Science Regulatory Assistant Recruitment
Genpact Life Science Regulatory Assistant Recruitment
Genpact Life Science Regulatory Assistant Recruitment - Apply Online. MSc Life Science candidates apply. Interested and eligible candidates can...
How & What To Study From CSIR NET Previous Year Question Papers
Strategies For Solving Previous Year CSIR Question Papers
CSIR NET exam is a national level exam conducted twice a year by the National Testing Agency...
Editing Plant Chromosomes Using CRISPR
CRISPR To Edit Plant Chromosomes - Combining Desired Traits In Crops
CRISPR/Cas9, also known as molecular scissors, is a technique widely used to modify genetic...
First 3D Map Of Heart’s Neurons
First 3D map of heart's neurons
Our body's control center - the brain maintains the regular performance of our hearts through an elaborate nerves network....
Israeli Defence Lab Scientists Find Gaucher’s Disease Drugs Effective Against COVID-19
New Drugs Found Effective Against Covid-19
Two drugs used to treat a genetic disorder called Gaucher’s disease have been found effective against coronavirus by the...
NII Cancer Project Recruitment – MSc Life Sciences Apply
NII Cancer Research Jobs - Life Science JRF Vacancy
NII Cancer Research Jobs - Life Science JRF Vacancy. Recruitment of MSc Life Science candidates at...
IIT Ropar MSc Plant Sciences Junior Research Fellow Job Opening
IIT Ropar Plant Sciences Job - Junior Research Fellow Post
IIT Ropar Plant Sciences Job - Junior Research Fellow Post. Candidates apply for a junior...
Delhi University Project Assistant Job – Biotech / Life Science / Microbiology
Delhi University Project Assistant Job - Biotech / Life Science / Microbiology
Delhi University Project Assistant Job - Biotech / Life Science / Microbiology. MSc/MTech...
Biotecnika Times – Newsletter 28.05.2020 – Govt Sickle Cell Biotech Job, ICAR-NBPGR Biotech
Biotecnika Times - Govt Sickle Cell Biotech Job, ICAR-NBPGR Biotech
Govt Sickle Cell Institute Biotech / Life Science Recruitment 2020
Govt Sickle Cell Institute Biotech /...